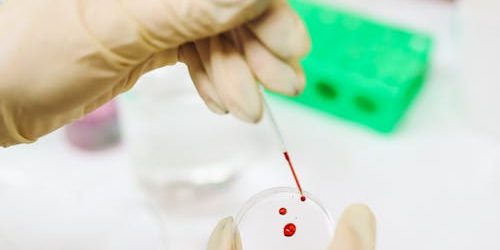
bild-messung tropfen bild-messung tropfen

Ab sofort bieten wir Ihnen Vitamin-D-, Blutzucker-, Blutfett- und Allergiemessungen an. Alle Messungen werden von unseren qualifizierten Mitarbeitern durchgeführt zuverlässig, sorgfältig und in angenehm diskreter Atmosphäre.
Die Ergebnisse liegen je nach Messung bereits nach wenigen Minuten bis spätestens nach etwa 15 Minuten vor.
Warum regelmäßige Gesundheitsmessungen wichtig sind:
Gesundheitswerte zu kennen bedeutet, besser informiert zu sein.
Unsere Messungen geben Ihnen einen schnellen Überblick über wichtige Körperwerte, helfen dabei, Ihren aktuellen Gesundheitszustand besser einzuschätzen und unterstützen Sie dabei, gut für sich zu sorgen.
Oft reicht bereits ein kurzer Check, um mehr Sicherheit und Klarheit zu gewinnen unkompliziert, schnell und direkt vor Ort.
Unsere Preise:
Kommen Sie jederzeit vorbei, wir sind für Sie da und begleiten Sie auf Ihrem Weg zu mehr Gesundheitsbewusstsein!